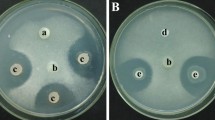

Abstract
The obligate biotrophic fungal pathogen Blumeria graminis causes the powdery mildew disease of cereals, which results in large crop losses. Control of B. graminis in barley is mainly achieved by fungicide treatment and by breeding resistant varieties. Vampyrellid amoebae, just like mycophagous protists, are able to consume a variety of fungi. To reveal the impact of some selected fungus-consuming protists on Blumeria graminis f. sp. hordei (Bgh), and to evaluate the possibility of using these protists as biological agents in the future, their feeding behaviour on B. graminis spores on barley leaves was investigated. An experiment was carried out with five different protist isolates (Leptophrys vorax, Platyreta germanica, Theratromyxa weberi U 11, Theratromyxa weberi G7.2 and Acanthamoeba castellanii) and four matched controls, including the food sources of the cultures and the medium. Ten-day-old leaves of barley (Hordeum vulgare cv. Golden Promise) were first inoculated with Blumeria graminis (f. sp. hordei race A6) spores, then treated with protists and fungal colonies on the leaf surfaces were counted under the microscope after 5 days. The isolates L. vorax, P. germanica, and T. weberi U11 did not show a significant reduction in the number of powdery mildew colonies whereas the isolates T. weberi G7.2 and A. castellanii significantly reduced the number of powdery mildew colonies on the leaf surfaces compared to their respective controls. This indicates that these two isolates are capable of reducing B. graminis colonies on barley leaves and are suitable candidates for further investigation for possible use as biological agents. Nevertheless, the susceptibility to dryness and the cell division rate should be considered during the optimisation of the next steps like application procedure and whole plant treatment.
Similar content being viewed by others
Avoid common mistakes on your manuscript.
Introduction
The crop barley was domesticated around 7800–7500 B.C. and is nowadays the fourth most important economically cultivated crop, besides wheat, rice and maize [1, 2]. The airborne obligate biotrophic fungus Blumeria graminis f. sp. hordei causes powdery mildew on barley, which is a major and damaging disease for cereal production in northern Europe [3]. It has a mixed reproductive system, with a sexual cycle during the growing season and an asexual cycle during the epidemic phase and is classified as a high-risk pathogen due to its large population size and high potential for adaptation [4, 5]. Growing resistant barley varieties is a good economically and environmentally friendly way to control the disease [6]. These resistant varieties are highly effective against the fungus, but research is time consuming, and some varieties have shown lower yield performance [6, 7]. Furthermore, the plant’s high anti-fungal efficacy only lasts for a short period of time, because of the production of various B. graminis f. sp. hordei virulence genes. During fungal sexual reproduction, new combinations of alleles are produced and distributed through asexual reproduction. These new combinations render the resistant plant varieties ineffective within a few years [6, 8]. Due to short-lived resistances, B. graminis f. sp. hordei is controlled by a combination of resistant varieties and fungicides, such as demethylation inhibitor (DMI) fungicides. In addition to the negative environmental impact of fungicides, such as run-off from agricultural land and accumulation in surrounding water bodies, this practice leads to the development of fungicide-resistant races of B. graminis f. sp. hordei. The appearance of resistant haplotypes can increase from 0 to 90% within two years and cause major economic problems for the barley production [9]. This calls for new, sustainable and environmentally friendly approaches, such as the use of biological control agents. Biological control agents are already being researched and used in several areas [10,11,12].
Vampyrellid amoebae from marine, freshwater and soil environments can feed on a wide range of different eukaryotes such as spores of fungi, diatoms and nematodes. They have the ability to engulf their prey whole or to perforate the cell wall [13]. Their feeding strategy depends on the prey species: Sericomyxa perlucida, for example, is able to engulf small diatoms and to feed on larger species by extraction of the protoplast with an invading pseudopodium [14]. The same was observed for Leptophrys vorax. L. vorax is able to engulf single algae cells, to engulf algae colonies or to invade them [15]. The order Vampyrellida includes several genera [16], and some examples are Leptophrys [17], Platyreta [18] and Theratromyxa [19]. Knowledge on the interactions between vampyrellid amoebae and fungi and nematodes raised interest on their use in agricultural pest control as biological control agents of soil-borne plant pathogens, such as the larvae of the nematode Heterodera rostochiensis [20]. It should be noted that the identification of the organisms may not be correct due to the imprecise methods of determination at the time. Soil inoculated with cysts of the nematode H. rostochiensis and the vampyrellid amoeba Theratromyxa showed that the amoebae was able to feed on the cysts, but the slow spread rate, the susceptibility to drought and the non-specific consumption of prey by the protists indicated that they were not suitable as biological agents [21]. The feeding behaviour of Theratromyxa weberi on the prey nematode Aphelenchoides rutgersi, which is a common pathogen of citrus plants, showed that the vampyrellid amoebae was able to engulf the prey in less than 3 h [22]. Arachnula impatiens and L. vorax were also tested on three different plant-parasitic nematodes, Meloidogyne incognita, Aphelenchoides besseyi and Helicotylenchus dihystera. The vampyrellid amoebae were able to feed on the three nematodes, and Arachnula impatiens was able to empty the larva of Meloidogyne incognita within 2–3 h, while L. vorax encysted the larva for 12–24 h [23]. Vampyrellid amoebae are also capable of lysing conidia and fungal spores [24]. Cochliobolus sativus inoculated with vampyrellid amoebae in different soils showed perforations and lysis of conidia [25]. Under cultural conditions, the amoebae Arachnula impatiens was able to perforate and lyse hyphae and chlamydospores of the fungus Phytophthora cinnamomi [25]. It was also reported that vampyrellid amoebae were able to perforate the hyphae of the plant pathogen Gaeumannomyces graminis, which causes the plant disease Take-all [26]. Opposing results were observed on the feeding behaviour of an unidentified vampyrellid amoebae on the fungi G. graminis var. tritici, Cochliobolus sativus and P. cinnamomi [27]. The unidentified vampyrellid amoebae showed no mycophagous behaviour and no perforations in the scanning electron microscope images. Nevertheless, it is suggested that vampyrellid amoebae have considerable potential for pathogen control through regulation of the rhizosphere microflora, leading to possible suppression of disease and favourable conditions for plant growth [28]. In addition to vampyrellid amoebae, genera like Acanthamoeba, which was previously thought to be a bacterivorous protist, were shown to be able to feed on various yeasts, but not on the hyphae of the fungus Fusarium culmorum [29], indicative of the existence of facultative mycophagous protists.
The aim of this study was to test for possible fungus-eating protists candidates to be used in further studies as biological control agents in agricultural crop production against the spores of fungal pathogens. Infected barley leaves were treated with different vampyrellid amoebae or mycophagous amoebae to observe their feeding on the spores of the plant pathogen Blumeria graminis f. sp. hordei race A6.
Material and Methods
Protist and Fungus Cultures
Five different amoeboid protists were selected for the experiment: Leptophrys vorax, Platyreta germanica, Theratromyxa weberi U11, Theratromyxa weberi G7.2 and Acanthamoeba castellanii. Acanthamoeba castellanii (strain CCAP 1534/3) was ordered from CCAP—Culture Collection of Algae and Protozoa (Oban, United Kingdom). Leptophrys vorax (strain CCAC 3424—Culture Collection of Algae at the University of Cologne (Cologne, Germany)), Platyreta germanica (strain CCAP 2559/1), Theratromyxa weberi U11 and Theratromyxa weberi G7.2 (strain CCAP 2573/1) were provided by Sebastian Hess (Institute for Zoology, University of Cologne, Cologne, Germany). L. vorax, P. germanica, T. weberi U11 and T. weberi G7.2 were fed with the yeast Saccharomyces cerevisiae H15, also provided by Sebastian Hess. The yeast was grown on malt extract agar (Carl Roth, Germany) at 25 °C in a climatic chamber. A. castellanii was fed with an unidentified mixture of Escherichia coli and various bacteria, obtained from the CCAP.
Blumeria graminis f. sp. hordei race A6 (hereafter: BghA6) was grown and maintained on small plants of the sensitive Scottish malting spring barley cv Golden Promise in a climate chamber at 22 °C/18 °C in a day/night cycle, 60% relative humidity and a 16 h photoperiod with 240 µmol m−2 s−1 photon flux density.
Blumeria graminis Spore Consumption in Liquid Cultures
In a first experiment, the ability of the protists to interact with and to consume BghA6 spores was tested at room temperature in half-strength Waris-H medium [30]. For the medium 0.50 ml of the stock solutions (stock solution in 1000 ml (final concentration in the media): HEPES 238 g (1 mM); KNO3 100 g (1 mM); MgSO4 × 7 H2O 20 g (81.1 µM); (NH4)2HPO4 20 g (0.15 mM); Ca(NO3)2 × 4 H2O 100 g (0.42 mM)) and 50 ml soil extract were added to 947.50 ml dH2O. For the soil extract, 10 g of grassland soil was mixed with 120 ml dH2O, boiled and stirred for 10 min on a hot plate. After the mixture was cooled down, it was filled in tubes (Sarstedt AG & Co. KG, Germany) and centrifuged at 1000g (Megafuge 1.OR, Thermo Fischer Scientific, USA) for 10 min. The supernatant was filtered through a 25 µm, 3 µm and 0.2 µm series of membrane filters (Whatman, United Kingdom), and the remaining filtrate was adjusted to 100 ml with dH2O (modified after the protocol of Central Collection of Algal Cultures). The medium was adjusted (Mettler-Toledo, Germany) to pH 7 with NaOH and autoclaved (HV-25L, HMC-Europe GmbH, Germany) at 121 °C for 20 min.
After counting the protist culture with a counting chamber (Neubauer improved, Hecht-Assistant, Germany) five millilitre of the 105 ml−1 protist culture was added to a large Petri dish (Ø 14.5 cm, 83.3903, Sarstedt AG & Co. KG, Germany) containing 100 ml of the medium, and then a barley plant infected with BghA6 was shaken over the open plate and the spores on the surface of the liquid culture were mixed by pipetting. After 1 week, the cultures were examined with the microscope under a 630× magnification (DM 1000 LED, Leica, Germany) to check for the consumption of the fungus spores by the protists. Microscopy was repeated after two, three and four weeks. Microscopy images were further processed and assembled using Pixlr Inmagine Lab (Pixlr X, Sweden), Corel PaintShop (Pro 2023, Canada) and ImageJ version 1.47 [31].
Infection of the Leaves with Blumeria graminis and Treatment with the Amoeboid Protists
The sensitive Scottish malting spring barley cv Golden Promise was used for the experiment. Ten Golden Promise seeds were sown in a small pot (Ø 6 cm) with a fertilized soil (type T, Fruhstorfer Erde, Hawita Gruppe, Germany) and grown in a climate chamber for ten days (conditions described above). Leaf segments were collected with sterile scissors and laid on 0.6% (wt/vol) water agar containing benzimidazole (0,0044%, Merck Schuchardt oHG, Germany). In detail, 6 g of agar (Roth, Germany) was added to 960 ml dH2O, autoclaved as described above and cooled. Benzimidazole solution (40 ml) was added to the water agar, shaken gently and poured into square Petri dishes. The leaf segments were fixed with sterile sticks in the square Petri dishes (Sarstedt AG & Co. KG, Germany) and inoculated with fresh spores of BghA6 (Fig. 1) in an inoculation tower. Specifically, six plates were opened and placed on the ground. A closed settling tower was placed above the plates and inoculated two times with three infected leaves by blowing spores from infected leaves inside the tower. The spore concentration was approximately 104 ml−1, determined by picking six similarly infected leaves, putting them in a glass bottle (Schott, Germany) with 100 ml half-strength Waris-H medium, washing the spores of by putting the bottle in an overhead shaker (Heidolph instruments GmbH & Co.KG, Germany) for 10 min with 1000 RPM and counting the spore concentration with the counting chamber (Neubauer improved). After the blowing, to ensure an even distribution of the spores, a metal distributor was swung into the tower, and the tower was closed again for 10 min, to allow the spores to settle down [3, 32]. Then the Petri dishes were closed and left at the climate chamber for 60 min for the initial contact. Besides the tower inoculation, some other methods (inoculation in suspension, inoculation with a pipette and a Drigalski spreader and inoculation by suspension spraying) were tested in a pre-experiment. The results (Tab. S1) showed that these other methods were not suitable for this experiment.
Overview of the inoculation steps in the experiment. Starting with the first true leaves of the Scottish malting spring barley cv Golden Promise on water agar with benzimidazole. Following by the inoculation with Blumeria graminis f. sp. hordei race A6 spores by blowing and the distribution of the treatments using a pipette and Drigalski spatula
One hour after the first inoculation, a second inoculation was made with the fungal consuming cultures. For the experiment, the protists were cultured (several replicates) one month before (as described above). L. vorax, P. germanica, T. weberi U11 and T. weberi G7.2 were fed with S. cerevisiae and A. castellanii was fed with a mixed bacterial culture. During the cultivation, the cultures were checked regularly by microscopy, fed with fresh prey and the plates were filled up with fresh half-strength Waris-H, if necessary. One day before the experiment, the cultures were examined under the microscope and cultures that showed good growth and high quality (high amount of trophozoites and several cysts) were selected and concentrated by centrifugation at 1000g for 10 min. The supernatant from A. castellanii culture was retained for a control treatment. All concentrated cultures were individually stored at room temperature in autoclaved glass bottles (one bottle per treatment). The experiment consisted of nine different treatments (Table 1). The first five treatments, i.e. the fungus-consuming cultures in half-strength Waris-H medium spread over BghA6-infected leaves and four control treatments. The control solutions consisted of the food sources (6) and (7) in half-strength Waris-H medium spread over BghA6-infected leaves, the medium (8) spread over BghA6-infected leaves and unaffected BghA6 spores (9) without a second inoculation. On each leaf of the plate, 1 ml of the protist culture 105 ml−1, determined with the counting chamber, was dripped with a pipette and spread over the surface of the central 1.5 cm section using a sterile Drigalski spreader. Five Petri dishes were prepared per treatment, with eight leaves in each Petri dish. The four control treatments (Table 1) were treated in the same way. For the first control (6), the number of remaining S. cerevisiae cells in the protist cultures was counted using the counting chamber. Based on the count results, a culture of S. cerevisiae in half-strength Waris-H with a concentration of 106 ml−1 was prepared, and the leaves were treated as described before. For the control (7), the remaining bacterial cells in the A. castellanii culture were counted with the counting chamber and the supernatant adjusted to the results of 107 bacteria ml−1. The inoculated plates were kept in the climate chamber for 5 days (same conditions as described previously) and covered with paper to create an environment without artificial light. This procedure was tested in a pre-experiment, where half-strength Waris-H medium was applied before and after the inoculation of BghA6 spores. It showed that the application of the medium before the BghA6 spores resulted in a slower colony development, with smaller colonies, in comparison to the chosen application method (Table S2).
Evaluation of the Powdery Mildew Colonies and Preparation of Microscopy Photographs
Four plates of each treatment were randomly selected and used for the evaluation. The central parts of the leaves were counted individually by placing a metal stencil with a 1 cm2 opening on the leaf. The powdery mildew colonies in this area were counted under a stereomicroscope (SZ-PT, Olympus, Japan).
Some of the infected leaves were used for subcultures, to see if the protists have survived the inoculation process and incubation time. Small pieces of the agar and from the central parts of the inoculated leaves were cut out with a scalpel (B. Braun, Germany). The agar and the leaf pieces were placed separately in Petri dishes and filled with half-strength Waris-H and S. cerevisiae. They were observed under the microscope after two days at room temperature.
Spraying of the Amoeboid Protists
Two parallel cultures of A. castellanii were used for a comparison of different spraying methods to investigate the potential for spraying protists on infected leaves. Only A. castellanii was chosen for this small side experiment, because it is smaller, more stable and has a fast reproduction rate in comparison to the other protists used in this experiment. The A. castellanii cultures were examined under a microscope, then one whole culture was sprayed with a brown glass spray bottle (Carl Roth, Germany) and the other culture was sprayed with a softer test tube sprayer (Duran, Germany) into a fresh Petri dish. After spraying, the cultures were left at room temperature for two hours and the cell shape was examined again under the microscope.
Statistical Analysis
Graphics and statistical analysis were performed using R version 4.0.3 [33]. Data were tested for normal distribution using the Shapiro–Wilk’s test [34], analysed using a non-parametric Kruskal–Wallis test [35] and a post hoc pairwise Wilcoxon rank sum test [36] (P < 0.05). To calculate the pairwise comparisons between the group levels, the P-values were multiplied by the number of comparisons by using the Benjamini & Hochberg adjustment method [37]. The package ggplot2 was used for the graph [38].
Results
Consumption of Blumeria graminis Spores by Protists in Liquid Cultures
The five different cultures were first tested for their ability to incorporate the BghA6 spores. The L. vorax, P. germanica, T. weberi U11 and T. weberi G7.2 trophozoites (Fig. 2) were able to ingest the BghA6 spores and produced active trophozoites. At the beginning of the experiment, a high amount of BghA6 spores and a low amount of trophozoites and several cysts were seen. The first ingestion of some BghA6 spores into the trophozoites could be seen in the L. vorax culture. After seven days, the number of BghA6 spores was reduced strongly and the number of L. vorax trophozoites and digestive cysts increased. Without any refreshment, a culture with active trophozoites could be observed for a period of seven days. After the vast majority of the reserves have been used up, the number of trophozoites decreased while that of cysts increased. Inside the trophozoites and digestive cysts, the spores did not show any signs of growth, while the non-incorporated spores started a formation of spore chains. In a slightly staggered chronological order, the same effect was seen for the cultures P. germanica, T. weberi U11 and T. weberi G7.2, dependent on the natural reproduction rate. The A. castellanii culture did not interact with the BghA6 spores in the liquid culture. Instead, the trophozoites disappeared and the number of cysts increased strongly.
Interaction of the vampyrellid trophozoites with BghA6 spores in a liquid half-strength Waris-H culture. a Incorporation of one BghA6 spore (arrow) into the active trophozoite of the protist L. vorax. b Incorporation of one BghA6 spore (arrow) into the active trophozoite of P. germanica. c Incorporation of one BghA6 spore (arrow) into the active trophozoite of the protist T. weberi U11. d Docking of a BghA6 spore (arrow) to the contracted trophozoite of T. weberi G7.2. Scale bar = 10 µm
Evaluation of the Powdery Mildew Colonies on the Golden Promise Leaves after Five Days
The number of powdery mildew colonies on the barley leaves showed a variable distribution of the 32 replicates of each treatment with several outliers (Fig. 3). All amoeboid treatments (1) L. vorax, (2) P. germanica, (3) T. weberi U11, (4) T. weberi G7.2 and (5) A. castellanii had smaller mean values compared to the four controls (6) S. cerevisiae, (7) Bacteria of A. castellanii, (8) half-strength Waris-H medium and (9) BghA6 only. The (4) T. weberi G7.2 treatment had the smallest median and mean value (x̄ = 9.1, XMed = 8.5), while the (9) BghA6 treatment had the largest median and mean value (x̄ = 29.9, XMed = 27.5).
Non-parametric Kruskal–Wallis statistical test showed significant differences between the treatments (P value = 9.3 × 10–12, P < 0.05). In addition, the post hoc pairwise Wilcoxon rank sum test also showed several significant differences between different treatments and their respective controls. Non suitable controls were not analysed (Table 2). T. weberi G7.2 and A. castellanii showed significant differences in the number of BghA6 colonies on the barley leaves compared to all of their respective controls, while the L. vorax, P. germanica and T. weberi U11 treatments did not. The A. castellanii treatment showed significantly fewer BghA6 colonies on the surface of the barley leaves compared to the control with the bacteria from the original culture, to the control with the media and to the control with the BghA6 spores only. The T. weberi G7.2 treatment also showed significantly fewer BghA6 colonies on the surface of the barley leaves compared to the S. cerevisiae control, to the media, and to the BghA6 spore control. L. vorax and P. germanica showed significantly fewer BghA6 colonies on the surface of the barley leaves compared to the S. cerevisiae and to the BghA6 spore control. The treatments did not show significantly less BghA6 colonies on the surface of the barley leaves compared to the control with the media. T. weberi U11 showed significantly fewer BghA6 colonies on the surface of the barley leaves compared to the BghA6 spore control. Compared to the control with the S. cerevisiae and the control with the media, the treatment did not show significantly less BghA6 colonies on the surface of the barley leaves. Furthermore, the T. weberi G7.2 treatment showed significantly fewer BghA6 colonies on barley leaves compared to the treatments P. germanica and T. weberi U11 (Table 3 and Fig. 3), while the other comparisons showed no significant differences.
The datasets generated during and/or analysed during the current study are available from the corresponding author upon reasonable request.
Viability Test of Inoculated Protists
The subcultures were prepared to check protist survival over five days at experimental conditions. For this purpose, the leaves and pieces of agar were examined under the microscope 2 days after preparation. L. vorax showed several cysts in the liquid cultures, as did P. germanica and T. weberi U11. The treatments A. castellanii and T. weberi G7.2 showed some cysts as well as active cells in the cultures in contact with the BghA6 spores (Fig. 4). In particular, the A. castellanii culture from the leaf material showed larger (approx. 20 µm) and deformed trophozoites, caused by the possible consumption of a fungal spore (Fig. 4a).
Spraying of Amoeboid Protists and Microscopy Evaluation
The culture, which was sprayed with a brown glass sprayer, was found to be partially lysed and had a battered appearance. The cysts of the A. castellanii culture appeared normal and unchanged, but the trophozoites were torn and damaged. The culture sprayed with the test tube sprayer had a better appearance. The cysts were unchanged and a few trophozoites could be detected, some were intact and active and some were ruptured.
Discussion
The liquid culture experiment was designed to demonstrate the possibility of amoeboid protists feeding on the spores of the obligate biotrophic fungal pathogen and causative agent of powdery mildew disease of cereals, Blumeria graminis. Several studies showed that vampyrellids are able to engulf and consume fungal spores [13, 24,25,26], but this has not been shown with Blumeria graminis f. sp. hordei (Bgh) spores so far. The isolates L. vorax, P. germanica, T. weberi U11 and T. weberi G7.2 were able to incorporate the BghA6 spores (Fig. 2). In contrast, the A. castellanii isolate did not clearly incorporate BghA6 spores in the liquid culture. While the vampyrellid amoebae have mostly been studied for their pest control potential [22, 23, 25], A. castellanii is usually fed with a bacterial food source [39,40,41,42] and not used for fungal feeding experiments, because they capture their prey by phagocytosis and are therefore not expected to be able to handle larger prey. However, the incorporation and growth of Acanthamoeba fed on the yeasts Saccharomyces cerevisiae and Cryptococcus laurentii has already been demonstrated [29]. A. castellanii is also able to feed on the yeasts Paracoccidioides spp. and Cryptococcus neoformans [43, 44]. However, it is also known that C. neoformans has evolved adaptations to protect itself against its predator: when phagocytosed by A. castellanii, C. neoformans is able to replicate inside the predator’s cell, leading it to its death [44]. The same protective mechanism has been observed in the fungus Aspergillus fumigatus [45]. In contrast, the ingestion of the spores of the fungus Fusarium culmorum and subsequent protist growth was not possible [29]. Perhaps, as already observed for hyphae [29], the BghA6 spores were too large to be phagocytosed by A. castellanii, and there was no secondary consumption pattern as in vampyrellid amoebae [14, 15]. Despite these observations in the liquid culture experiment, all isolates were able to influence the BghA6 spores within five days and to survive on the barley’s leaf surface (Fig. 3). The protists L. vorax, P. germanica and T. weberi U11 showed cysts in the subcultures and the re-isolates A. castellanii and T. weberi G7.2 showed cysts and incorporated BghA6 spores after the experiment (Fig. 4). It is particularly interesting that A. castellanii was able to incorporate the BghA6 spores on the leaf surface: the trophozoites of the culture survived and were able to consume the spores (Fig. 4a), contrary to the results of the liquid culture experiment and previous knowledge. This finding requires further and more intensive research to understand the mechanisms behind the phagocytosis of the large spore, especially since a repetition of the experiment showed the same results (Table S3). The number of mildew colonies on the leaves confirmed the activity of the protist isolates, as all treatments with isolates showed significantly fewer mildew colonies compared to the control with BghA6 spores only. The isolate T. weberi U11 was significantly different from the control with BghA6 spores only, but not from the controls with the half-strength Waris-H medium and S. cerevisiae. However, it is not possible to determine exactly whether the observed effect is caused by the T. weberi U11, by the residual food source S. cerevisiae or the medium. On the one hand, the remaining food source S. cerevisiae could affect the BghA6 spores. It was shown that extracts from S. cerevisiae could control powdery mildew on barley by disrupting the fungal penetration [46]. Furthermore, it was suggested that S. cerevisiae is a potential alternative to chemical fungicides in the grape production for the prevention and control of powdery mildew [47]. There are also a number of products on the market that use S. cerevisiae to control powdery mildew (e.g. Romeo®, Intrachem Bio Deutschland GmbH & Co. KG, Germany). On the other hand, the liquid medium could interfere with fungal penetration by washing away the BghA6 spores. The L. vorax and P. germanica isolates showed significantly fewer powdery mildew colonies than the BghA6 spores-only control and the S. cerevisiae control. This means that the residual food source S. cerevisiae most likely did not cause the measured effect. In spite of this, there was no significant difference compared to the control with half-strength Waris-H. This means that the effect could be caused by the half-strength Waris-H medium by washing off the spores. The two treatments A. castellanii and T. weberi G7.2 showed significant differences in comparison to all of their controls with the food source S. cerevisiae or the bacteria of A. castellanii, with the half-strength Waris-H media and the BghA6 spores only. Therefore, the effect is most likely caused by the treatments and not by any other kind of interference. Combined with the results of the post-experiment subcultures, where active trophozoites were found in both cultures, it is most likely that the cells of these treatments were able to consume various attached microorganisms and many of the BghA6 spores on the barley leaves (Fig. 3). Again interestingly, A. castellanii was able to feed on the BghA6 spores from the leaves, something that had not been demonstrated in the liquid culture experiment or in the literature. Perhaps because there was no other viable food source in sufficient quantity, the pressure to survive led to the consumption of BghA6 spores. Furthermore, T. weberi G7.2 showed significantly fewer powdery mildew colonies on the barley leaves compared to the P. germanica and T. weberi U11 treatments. This suggests a possible use of the two fungus-consuming protists A. castellanii and T. weberi G7.2 as controlling agents of fungal infections by powdery mildew in the organic farming to optimise crop production, like it was already tried with the vampyrellid amoeba and the plant-damaging fungi Gaeumannomyces graminis [26]. However, others also tested T. weberi as a biological control agent and found that the trophic stages were not present fast enough due to the slow spread rate [21, 48]. Additional exclusion criteria such as drought susceptibility and non-specific feeding behaviour have to be considered before an application of T. weberi as a biological control agent, since the trophozoites had less drought stress in this experimental design, as they would have on normal leaves of a plant over a longer period of time. Nevertheless, in this experiment, the protists showed good potential for an environmentally friendly pest control product and the additional spraying test showed that further experiments would be useful. For this reason, T. weberi G7.2 and A. castellanii are optimal candidates for more intensive research into the control of powdery mildew on leaf surfaces, as they significantly reduced the number of mildew colonies and survived well on the barley leaf surface. This offers the prospect of reducing chemical fungicide use and possibly improve biological pathogen control for barley plants.
Conclusion
All five protist isolates (L. vorax, P. germanica, T. weberi U11, T. weberi G7.2 and A. castellanii) were able to consume the BghA6 spores. The best results were obtained with the isolates T. weberi G7.2 and A. castellanii, which showed a significant reduction of powdery mildew colonies on the barley leaf surface compared to their respective controls. Based on several previous experiments and the results obtained in this study, further research is needed to confirm whether the two isolates T. weberi G7.2 and A. castellanii have potential for use as biological control agents against fungal infections with powdery mildew. Further studies could focus on the application procedure of protists on plants and their survival on the leaf surface and further experiments on plants in the greenhouse will give insights on spread rates of protists and susceptibility to drought [21].
Data availability
Data, material and codes can be provided upon request.
References
Nesbitt M, Samuel D (1996) From staple crop to extinction? The archaeology and history of the hulled wheats. Hulled wheats 4:41–100
Chełkowski J, Tyrka M, Sobkiewicz A (2003) Resistance genes in barley (Hordeum vulgare L.) and their identification with molecular markers. J Appl Genet 44:291–309
Lyngkjær MF, Carver TLW (1999) Induced accessibility and inaccessibility to Blumeria graminis f.sp. hordei in barley epidermal cells attacked by a compatible isolate. Physiol Mol Plant Pathol 55:151–162
Dreiseitl A (2003) Methods and results of investigation of Blumeria Graminis f. sp. hordei populations. Becтник зaщиты pacтeний 1:59–62
McDonald BA, Linde C (2002) Pathogen population genetics, evolutionary potential, and durable resistance. Annu Rev Phytopathol 40:349–379
Piechota U, Słowacki P, Czembor PC (2020) Identification of a novel recessive gene for resistance to powdery mildew (Blumeria graminis f. sp. hordei) in barley (Hordeum vulgare). Plant Breed 139:730–742
Pham TAT, Schwerdt JG, Shirley NJ, Xing X, Bulone V, Little A (2019) Composition and biosynthetic machinery of the Blumeria graminis f. sp. hordei conidia cell wall. Cell Surf 5:100029
Dreiseitl A (2003) Adaptation of Blumeria graminis f.sp. hordei to barley resistance genes in the Czech Republic in 1971–2000. Plant Soil Environ 49:241–248
Tucker MA, Lopez-Ruiz F, Cools HJ, Mullins JGL, Jayasena K, Oliver RP (2019) Analysis of mutations in West Australian populations of Blumeria graminis f. sp. hordei CYP51 conferring resistance to DMI fungicides. Pest Manag Sci 76:1265–1272
Zhao J, Wu YX, Ho HH, Chen ZJ, Li XY, He YQ (2016) PBT1, a novel antimicrobial protein from the biocontrol agent Bacillus subtilis XF-1 against Plasmodiophora brassicae. Eur J Plant Pathol 145:583–590
Cho CF, Lee WC (1999) Formulation of a biocontrol agent by entrapping biomass of Trichoderma viride in gluten matrix. J Biosci Bioeng 87:822–824
Schmiedeknecht G, Bochow H, Junge H (1998) Use of Bacillus subtilis as biocontrol agent. J Plant Dis Prot 105:376–386
Old KM, Darbyshire JF (1978) Soil fungi as food for giant amoebae. Soil Biol Biochem 10:93–100
More K, Simpson AGB, Hess S (2021) Description of the marine predator Sericomyxa perlucida gen. et sp. nov., a cultivated representative of the deepest branching lineage of vampyrellid amoebae (Vampyrellida, Rhizaria). J Eukaryot Microbiol 68:1–14
Hess S (2017) Hunting for agile prey: trophic specialisation in leptophryid amoebae (Vampyrellida, Rhizaria) revealed by two novel predators of planktonic algae. FEMS Microbiol 93:1–12
Hess S, Suthaus A (2021) The vampyrellid Amoebae (Vampyrellida, Rhizaria). Protist 173:125854
Hertwig R, Lesser E (1874) Über Rhizopoden und denselben nahestehenden Organismen. Verlag von Max Cohen & Sohn, Bonn
Bass D, Howea AT, Mylnikovb AP, Vickermanc K, Chaoa EE, Smallbonea JE, Snella J, Jra CC, Cavalier-Smith T (2009) Phylogeny of novel naked filose and reticulose Cercozoa: Granofilosea cl. n. and Proteomyxidea Revised. Protist 160:75–109
Zwillenberg LO (1952) Theratromyxa Weberi, a new proteomyxean organism from soil. Ant Leeuw 19:101–116
Weber A, Zwillenberg LO, Van der Laan PA (1952) A predacious amceboid organism destroying larvae of the potato root eelworm and other nematodes. Nature 169:834–835
Van der Laan PA (1954) Nader onderzoek over het aaltjesvangende amoeboide organisme Theratromyxa weberi Zwillenberg. Tijdschr Plantenziekten 60:139–145
Sayre RM, Wergin WP (1989) Morphology and fine structure of the trophozoites of Theratromyxa weberi (Protozoa: Vampyrellidae) predacious on soil nematodes. Can J Microbiol 35:589–602
Homma Y, Kegasawa K (1984) Predation on larvae of plant parasitic amoebae. Japanese J Nematol 14:1–3
Anderson TR, Patrick ZA (1978) Mycophagous amoeboid organisms from soil that perforate spores of Thielaviopsis basicola and Cochliobolus sativus. Phytopathology 68:1618–1626
Old KM, Oros JM (1980) Mycophagous amoebae in Australian forest soils. Soil Biol Biochem 12:169–175
Homma Y, Sitton JW, Cook RJ, Old KM (1979) Perforation and destruction of pigmented hyphae of Gaeumannomyces graminis by Vampyrellid amoeba from Pacific Northwest wheat field soils. Phytopathology 69:1118–1122
Chakraborty S, Old KM, Warcup JH (1983) Amoebae from a take-all suppressive soil which feed on Gaeumannomyces graminis tritici and other soil fungi. Soil Biol Biochem 15:17–24
Curl EA, Old KM (1988) The role of soil microfauna in plant-disease suppression. CRC Crit Rev Plant Sci 7:175–196
Geisen S, Koller R, Hünninghaus M, Dumack K, Urich T, Bonkowski M (2016) The soil food web revisited: diverse and widespread mycophagous soil protists. Soil Biol Biochem 94:10–18
Mcfadden GI, Melkonian M (1986) Use of Hepes buffer for micro algal culture media and fixation for electron microscopy. Phycologia 25:551–557
Schneider CA, Rasband WS, Eliceiri KW (2012) NIH Image to ImageJ: 25 years of image analysis. Nat Methods 9:671–675
Dey S, Wenig M, Langen G, Sharma S, Kugler KG, Knappe C, Hause B, Bichlmeier M, Babaeizad V, Imani J, Janzik I, Stempfl T, Hückelhoven R, Kogel KH, Mayer KFX, Vlo AC (2014) Bacteria-triggered systemic immunity in barley is associated with WRKY and ETHYLENE RESPONSIVE FACTORs but not with salicylic acid. Plant Physiol 166:2133–2151
R Core Team (2020) R: a language and environment for statistical computingle. R Foundation for Statistical Computing, Austria
Shapiro SS, Wilk MB (1965) An analysis of variance test for normality (complete samples). Biometrika 52:591
Kruskal WH, Wallis WA (1952) Use of ranks in one-criterion variance analysis. J Am Stat Assoc 47:583–621
Wilcoxon F (1945) Individual comparisons by ranking methods. Biom Bull 1:80–83
Benjamini Y, Hochberg Y (1995) Controlling the false discovery rate: a practical and powerful approach to multiple testing. J R Stat Soc Ser B 57:289–300
Wickham H (2016) Ggplot2: elegant graphics for data analysis. Springer Verlag, New York
Bonkowski M, Brandt F (2002) Do soil protozoa enhance plant growth by hormonal effects? Soil Biol Biochem 34:1709–1715
Kreuzer K, Adamczyk J, Iijima M, Wagner M, Scheu S, Bonkowski M (2006) Grazing of a common species of soil protozoa (Acanthamoeba castellanii) affects rhizosphere bacterial community composition and root architecture of rice (Oryza sativa L.). Soil Biol Biochem 38:1665–1672
Krome K, Rosenberg K, Dickler C, Kreuzer K, Ludwig-Müller J, Ullrich-Eberius C, Scheu S, Bonkowski M (2010) Soil bacteria and protozoa affect root branching via effects on the auxin and cytokinin balance in plants. Plant Soil 328:191–201
Weidner S, Latz E, Agaras B, Valverde C, Jousset A (2017) Protozoa stimulate the plant beneficial activity of rhizospheric pseudomonads. Plant Soil 410:509–515
Albuquerque P, Nicola AM, Gomes Magnabosco DA, da Silveira Derengowski L, Crisóstomo LS, Gomes Xavier LC, de Oliveira Frazão S, Guilhelmelli F, de Oliveira MA, do Nascimento Dias J, Hurtado FA, de MeloTeixeira M, Guimarães AJ, Paes HC, Bagagli E, Soares Felipe MS, Casadevall A, Silva-Pereira I (2019) A hidden battle in the dirt: soil amoebae interactions with Paracoccidioides spp. PLoS Negl Trop Dis 13:e0007742
Steenbergen JN, Shuman HA, Casadevall A (2001) Cryptococcus neoformans interactions with amoebae suggest an explanation for its virulence and intracellular pathogenic strategy in macrophages. Proc Natl Acad Sci USA 98:15245–15250
Van Waeyenberghe L, Baré J, Pasmans F, Claeys M, Bert W, Haesebrouck F, Houf K, Martel A (2013) Interaction of Aspergillus fumigatus conidia with Acanthamoeba castellanii parallels macrophage-fungus interactions. Environ Microbiol Rep 5:819–824
Reglinski T, Lyon GD, Newton AC (1994) Induction of resistance mechanisms in barley by yeast-derived elicitors. Ann Appl Biol 124:509–517
Singh PN (2017) Biocontrol of powdery mildew of grapes using culture filtrate and biomass of fungal isolates. Plant Pathol Quar 7:181–189
Sayre RM (1973) Theratromyxa weberi, an amoeba predatory on plant-parasitic nematodes. J Nematol 5:258–264
Acknowledgements
In addition to the financial support of the German Federal Environment Foundation (Deutsche Bundesstiftung Umwelt), the authors would like to thank Rita Geißler-Plaum, Ute Micknass and Jennifer Thielmann for their technical assistance. The authors would also like to thank Sebastian Hess (Institute of Zoology, University of Cologne, Germany) for providing the cultures and commenting on the manuscript.
Funding
Open Access funding enabled and organized by Projekt DEAL. This work was supported by a fully funded doctoral scholarship for Julia Sacharow from the German Federal Environment Foundation (Deutsche Bundesstiftung Umwelt).
Author information
Authors and Affiliations
Contributions
All authors contributed to the study conception and design. Pre-experiments, data collection and analysis were performed by Elnaz Salehi-Mobarakeh. Statistical analysis, first and final drafts of the manuscript were prepared by Julia Sacharow. All authors commented on previous versions of the manuscript, as well as read and approved the final manuscript.
Corresponding author
Ethics declarations
Hordeum vulgare cv. Golden Promise plants and the Blumeria graminis f. sp. hordei race A6 fungi were utilized.
Conflict of interest
This work was supported by a fully funded doctoral scholarship for Julia Sacharow from the German Federal Environment Foundation (Deutsche Bundesstiftung Umwelt). Furthermore, financial support for attending symposia was provided with the scholarship.
Consent for publication
Not applicable.
Consent to participate
Not applicable.
Ethics approval
Not applicable.
Additional information
Publisher's Note
Springer Nature remains neutral with regard to jurisdictional claims in published maps and institutional affiliations.
Supplementary Information
Below is the link to the electronic supplementary material.
Rights and permissions
Open Access This article is licensed under a Creative Commons Attribution 4.0 International License, which permits use, sharing, adaptation, distribution and reproduction in any medium or format, as long as you give appropriate credit to the original author(s) and the source, provide a link to the Creative Commons licence, and indicate if changes were made. The images or other third party material in this article are included in the article's Creative Commons licence, unless indicated otherwise in a credit line to the material. If material is not included in the article's Creative Commons licence and your intended use is not permitted by statutory regulation or exceeds the permitted use, you will need to obtain permission directly from the copyright holder. To view a copy of this licence, visit http://creativecommons.org/licenses/by/4.0/.
About this article
Cite this article
Sacharow, J., Salehi-Mobarakeh, E., Ratering, S. et al. Control of Blumeria graminis f. sp. hordei on Barley Leaves by Treatment with Fungi-Consuming Protist Isolates. Curr Microbiol 80, 384 (2023). https://doi.org/10.1007/s00284-023-03497-5
Received:
Accepted:
Published:
DOI: https://doi.org/10.1007/s00284-023-03497-5